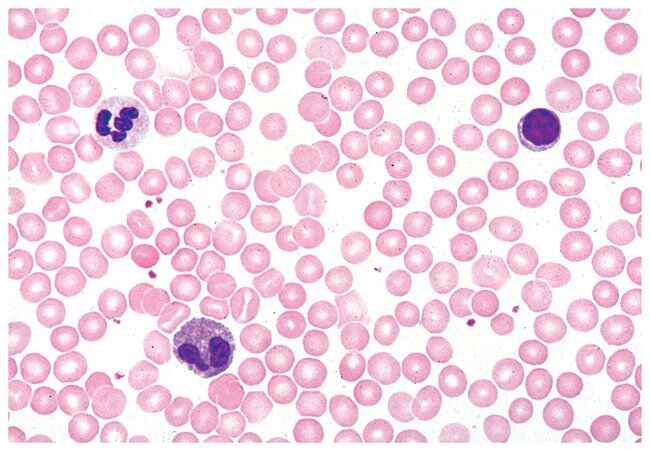

Prepared Individual Microscope Slides, High-Quality Microscope Slides, Manufactured Under Rigorous Control To Meet All Scientific Requirements, Each
$ 18.78
|
|
Details:
Premium glass with fine ground edgesSize: 1 × 3 in. (26 × 76mm)Specially stained to ensure a clear, multicolored representation of all tissue structuresSpecimens are characteristic and representative of the taxonomic group and/or subjectAll slides sold separately
Additional Information
| SKU | 1333511 |
|---|---|
| UOM | Each |
| UNSPSC | 41122601 |
| Manufacturer Part Number | MA1902C |
